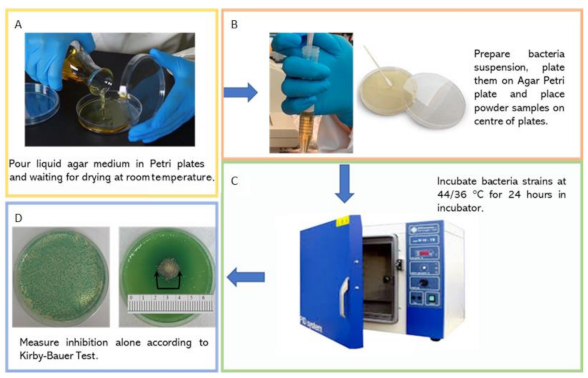
Applsci 12 00434 g001

A New System of Sustainable Silico-Aluminous and Silicate Materials for Cultivation Purpose within Sustainable Buildings: Chemical-Physical, Antibacterial and Cytotoxicity Properties
Abstract
:1. Introduction
- it is possible to control the whole crop, including the temperature, the time of exposure of plants to light, and when the plant will receive water;
- gives year-round cultivation regardless of season;
- it is possible to harvest more quickly since in an indoor crop gives to control the photoperiod of the plants;
- less exposure to pests or other bugs;
- it is a zero-kilometer technique;
- it allows the saving of more than 90% of water compared with traditional crops;
- any space can be used: just have the accessories and assemble your own grow;
- by having space, it is also possible to place multiple overlapping indoor crops (the so-called vertical farms);
- there is no dependence on sunlight, but it is necessary to have a suitable kit of lights that can recreate the optimal growth atmosphere for plants. Many also use the most modern LED lamps to decrease production costs.
2. Materials and Methods
2.1. Starting Materials and Mixtures
2.2. Chemical-Physical Parameters
2.3. Leaching Test
2.4. Antibacterial Activity
2.5. Cytotoxicity
3. Results and Discussion
3.1. Chemical-Physical Parameters
3.1.1. Density and Porosity
3.1.2. pH and Electrical Conductivity
3.2. Leaching Test
3.3. Antibacterial Activity
3.4. Cytotoxicity
4. Conclusions
Author Contributions
Funding
Institutional Review Board Statement
Informed Consent Statement
Data Availability Statement
Conflicts of Interest
References
- ISPRA. Verde Pensile: Prestazioni di Sistema e Valore Ecologico, Manuali e Linee Guida; 78.3/2012; ISPRA: Roma, Italy, 2012; ISBN 978-88-448-0534-0. [Google Scholar]
- Piesse, M. Global Food and Water Security in 2050: Demographic Change and Increased Demand, Future Directions International; Strategic Analysis Paper; Future Directions International: Nedlands, Australia, 2020; pp. 1–6. [Google Scholar]
- Change in Cereal Production, Yeld and Land Use, World, 1961 to 2018, OWD Based on World Bank and UNI FAO. Available online: https://ourworldindata.org/grapher/index-of-cereal-production-yield-and-landuse?country=~OWID_WRL (accessed on 10 October 2021).
- Parrotta, L.; Guerriero, G.; Sergeant, K.; Cai, G.; Hausman, J.F. Target or barrier? The cell wall of early and later-diverging plants vs cadmium toxicity: Differences in the response mechanism. Front. Plant Sci. 2015, 6, 133. [Google Scholar] [CrossRef] [PubMed] [Green Version]
- Barbieri, L.; Andreola, F.; Bellucci, D.; Cannillo, V.; Lancellotti, I.; Lugari, A.; Rincòn, J.M.; Romero, M.; Sola, A. Preliminary studies on the valorization of animal flour ash for the obtainment of active glasses. Ceram. Int. 2014, 40, 5619–5628. [Google Scholar] [CrossRef] [Green Version]
- Farias, R.D.; Garcia, C.M.; Palomino, T.C.; Andreola, F.; Lancellotti, I.; Barbieri, L. Valorization of Agro-Industrial Wastes in Lightweight Aggregates for Agronomic Use: Preliminary Study. Environ. Eng. Manag. J. 2017, 16, 1691–1699. [Google Scholar] [CrossRef]
- Andreola, F.; Borghi, A.; Pedrazzi, S.; Allesina, G.; Tartari, P.; Lancellotti, I.; Barbieri, L. Spent Coffee Grounds in the Production of Lightweight Clay Ceramic Aggregates in View of Urban and Agricultural Sustainable Development. Materials 2019, 12, 3581. [Google Scholar] [CrossRef] [PubMed] [Green Version]
- Andreola, F.; Lancellotti, I.; Manfredini, T.; Barbieri, L. The circular economy of agro and post-consumer residues as raw materials for sustainable ceramics. Int. J. Appl. Ceram. Technol. 2019, 17, 22–31. [Google Scholar] [CrossRef]
- Barbieri, F.; Barbi, S.; Andreola, F.; Lancellotti, I.; Garcia, C.M.; Palomino, T.C.; Montorsi, M.; Barbieri, L. Design and Characterization of Controlled Release pk Fertilizers from Agro-Residues. Environ. Eng. Manag. J. 2020, 19, 1669–1676. [Google Scholar] [CrossRef]
- Barbi, S.; Barbieri, F.; Andreola, F.; Lancellotti, I.; Barbieri, L.; Montorsi, M. Preliminary Study on Sustainable NPK Slow-Release Fertilizers Based on Byproducts and Leftovers: A Design-of-Experiment Approach. ACS Omega 2020, 5, 27154–27163. [Google Scholar] [CrossRef] [PubMed]
- Ronga, D.; Parisi, M.; Barbieri, L.; Lancellotti, I.; Andreola, F.; Bignami, C. Valorization of Spent Coffee Grounds, Biochar and other residues to Produce Lightweight Clay Ceramic Aggregates Suitable for Nursery Grapevine Production. Horticulturae 2020, 6, 58. [Google Scholar] [CrossRef]
- Martínez-García, C.; Andreola, F.; Lancellotti, I.; Farías, R.; Cotes-Palomino, M.; Barbieri, L. Cleaner Design and Production of Lightweight Aggregates (LWAs) to Use in Agronomic Application. Appl. Sci. 2021, 11, 800. [Google Scholar] [CrossRef]
- Barbieri, L.; Bigi, A.; Andreola, F.; Lancelotti, I.; Ghermandi, G.; Palomino, M.T.C.; García, C.M. Environmental impact estimation of ceramic lightweight aggregates production starting from residues. Int. J. Appl. Ceram. Technol. 2021, 18, 353–368. [Google Scholar] [CrossRef]
- EN 13037:2011; Soil Improvers and Growing Media—Determination of pH. European Standard: Pilsen, Czech Republic, 2011.
- EN 13038:2011; Soil Improvers and Growing Media—Determination of Electrical Conductivity. European Standard: Pilsen, Czech Republic, 2011.
- UNI EN 12457-2:2004; Waste Characterization—Leaching Test—Conformity Test for Leaching of Granular Waste and Sludge—Part 2: One-Stage Test, with a Liquid/Solid Ratio of 10 L/kg, for Materials with Particles Smaller than 4 mm (with or without Reduction of Dimensions). European Standard: Pilsen, Czech Republic, 2011.
- UNI EN ISO 11885:2009; Water Quality—Determination of Certain Elements by Inductively Coupled Plasma Optical Emission Spectrometry. European Standard: Pilsen, Czech Republic, 2011.
- EPA 2018; Method 6010D (SW-846): Inductively Coupled Plasma-Atomic Emission Spectrometry. U.S. EPA: Washington, DC, USA, 2018.
- APAT CNR IRSA 4020 Man 29 2003; Roma 2004Determination of Anions (Fluoride, Chloride, Nitrite, Bromide, Nitrate, Phosphate and Sulphate) by Ion Chromatography. Available online: https://www.arpal.liguria.it/images/stories/metodi_scarichi_rev01.pdf (accessed on 20 December 2021).
- APAT CNR IRSA 4110; Analytic Methods for Water—Phosphorus (Orthophosphate; Total Phosphorus). Available online: http://www.appa.provincia.tn.it/binary/pat_appa_restyle/tariffario/ElencoProveSL_19012016.1453198719.pdf (accessed on 20 December 2021).
- UNI EN 12260:2004; Water Quality—Determination of Nitrogen—Determination of Bound Nitrogen (TNb) after Oxidation to Nitrogen Oxides. European Standard: Pilsen, Czech Republic, 2004.
- Catauro, M.; D’Errico, Y.; D’Angelo, A.; Clarke, R.J.; Blanco, I. Antibacterial Activity and Iron Release of Organic-Inorganic Hybrid Biomaterials Synthesized via the Sol-Gel Route. Appl. Sci. 2021, 11, 9311. [Google Scholar] [CrossRef]
- EN 13055:2016; Lightweight Aggregates. European Standard: Pilsen, Czech Republic, 2016.
- Legislative Decree 29 April 2010, n. 75—Reorganization and Revision of the Regulations on Fertilizers (in Italian); Ministry of Agricultural, Food and Forestry Policies: Roma, Italy, 2010.
- Katsikogianni, M.; Missirlis, Y. Concise review of mechanisms of bacterial adhesion to biomaterials and of techniques used in estimating bacteria-material interactions. Eur. Cells Mater. 2004, 8, 37–57. [Google Scholar] [CrossRef] [PubMed]
- Andreola, F.; Barbieri, L.; Soares, B.Q.; Karamanov, A.; Schabbach, L.; Bernardin, A.M.; Pich, C.T. Toxicological analysis of ceramic building materials—Tiles and glasses—Obtained from post-treated bottom ashes. Waste Manag. 2019, 98, 50–57. [Google Scholar] [CrossRef] [PubMed]
- Zhang, X.; Aoyama, T.; Yasuda, T.; Oike, M.; Ito, A.; Tajino, J.; Nagai, M.; Fujioka, R.; Iijima, H.; Yamaguchi, S.; et al. Effect of microfabricated microgroove-surface devices on the morphology of mesenchymal stem cells. Biomed. Microdevices 2015, 17, 116. [Google Scholar] [CrossRef] [PubMed]

| Sample Code | Composition |
|---|---|
| FG1 | Fertilizer glass (packaging glass cullet + K2CO3 + cattle bone flour ash (P)) |
| FG2 | Fertilizer glass (packaging glass cullet + vegetable biomass ash (K) + cattle bone flour ash (P)) |
| FG3 | Fertilizer glass (pumice scrap + K2CO3 + cattle bone flour ash (P)) |
| C | LWAs (clay + spent coffee grounds) |
| CFG2 | LWAs (clay + spent coffee grounds) + FG2 |
| CNUT2 | LWAs (clay + spent coffee grounds) + nutrients of FG2 non-vitrified |
| CP | LWAs (clay/pumice + spent coffee grounds) |
| CPFG3 | LWAs (clay/pumice + spent coffee grounds) + FG3 |
| CPNUT3 | LWAs (clay/pumice + spent coffee grounds) + nutrients of FG3 non-vitrified |
| CPFG3N1 | LWAs (clay/pumice + spent coffee grounds) + FG3 with nitrogen-based coating extracted from black soldier fly |
| CPFG3N2 | LWAs (clay/pumice + spent coffee grounds) + FG3 with commercial nitrogen-based coating |
| METALS | SAMPLE | ||||||
|---|---|---|---|---|---|---|---|
| FG1 | FG2 | FG3 | CPFG3 | CPNUT3 | CPFG3N1 | CPFG3N2 | |
| Al | 484.62 | 114.58 | 634.1 | 960.1 | 69.52 | 203.08 | 120.3 |
| As | 10.66 | 11.04 | <2 | <2 | 5.3 | 5.95 | 54.2 |
| B | 115.72 | 199.79 | 60.4 | 153.2 | 4.94 | 3.92 | 160.4 |
| Ba | <2 | <2 | <2 | <2 | <2 | <2 | <2 |
| Be | <2 | <2 | <2 | <2 | <2 | <2 | 2.9 |
| Cd | <2 | <2 | <2 | <2 | <2 | <2 | <2 |
| Co | <2 | <2 | <2 | <2 | <2 | <2 | <2 |
| Cr | 11.54 | 5.21 | <2 | 12,85 | <2 | 3.82 | <2 |
| Cu | 4.64 | 3.69 | 4.1 | 4.43 | <2 | <2 | <2 |
| Fe | 244.92 | 70.22 | 39.84 | 154.3 | 13.76 | 2.94 | 161.6 |
| Mn | 5.34 | 4.58 | <2 | 22,4 | <2 | <2 | 47.8 |
| Mo | <2 | 2.26 | <2 | 31.64 | <2 | 12.9 | 225.21 |
| Ni | 39.31 | 39.23 | 9.47 | 5.7 | <2 | <2 | 7.67 |
| Pb | <2 | 2.82 | <2 | 10.1 | <2 | <2 | 3.45 |
| Sb | 9.18 | 10.79 | 2.6 | 5.79 | 2.02 | <2 | 6.09 |
| Se | 2.24 | <2 | <2 | <2 | <2 | <2 | 7.49 |
| Sn | 10.39 | 4.8 | 2.13 | 16.62 | 3.24 | 7.02 | <2 |
| Tl | <2 | 2.33 | 2.66 | 23.5 | 4.55 | 2.22 | <2 |
| V | 24.01 | 11.02 | 63.1 | >400 | 40.77 | 65.39 | 62.99 |
| Zn | 18.14 | 17.92 | 6.83 | 13.32 | <2 | 4.53 | 6.03 |
| SAMPLE | |||||||
|---|---|---|---|---|---|---|---|
| FG1 | FG2 | FG3 | CPFG3 | CPNUT3 | CPFG3N1 | CPFG3N2 | |
| PO43− | <0.5 | <0.5 | <0.5 | 0.741 | 0.821 | 2.41 | 7.1 |
| P Tot | 0.543 | 0.672 | 0.966 | 2 | 2.5 | 130 | 23.1 |
| NO3− | - | - | - | - | - | 0.7 | 0.7 |
| N tot | - | - | - | - | - | 9.516 | 1.672 |
| K tot | 169.56 | 210.56 | 130.64 | 25.21 | 44.54 | 155.99 | 44.1 |
Publisher’s Note: MDPI stays neutral with regard to jurisdictional claims in published maps and institutional affiliations. |
© 2022 by the authors. Licensee MDPI, Basel, Switzerland. This article is an open access article distributed under the terms and conditions of the Creative Commons Attribution (CC BY) license (https://creativecommons.org/licenses/by/4.0/).
Share and Cite
Catauro, M.; Dal Poggetto, G.; Pacifico, S.; Andreola, F.; Lancellotti, I.; Barbieri, L. A New System of Sustainable Silico-Aluminous and Silicate Materials for Cultivation Purpose within Sustainable Buildings: Chemical-Physical, Antibacterial and Cytotoxicity Properties. Appl. Sci. 2022, 12, 434. https://doi.org/10.3390/app12010434
Catauro M, Dal Poggetto G, Pacifico S, Andreola F, Lancellotti I, Barbieri L. A New System of Sustainable Silico-Aluminous and Silicate Materials for Cultivation Purpose within Sustainable Buildings: Chemical-Physical, Antibacterial and Cytotoxicity Properties. Applied Sciences. 2022; 12(1):434. https://doi.org/10.3390/app12010434
Chicago/Turabian StyleCatauro, Michelina, Giovanni Dal Poggetto, Severina Pacifico, Fernanda Andreola, Isabella Lancellotti, and Luisa Barbieri. 2022. "A New System of Sustainable Silico-Aluminous and Silicate Materials for Cultivation Purpose within Sustainable Buildings: Chemical-Physical, Antibacterial and Cytotoxicity Properties" Applied Sciences 12, no. 1: 434. https://doi.org/10.3390/app12010434
APA StyleCatauro, M., Dal Poggetto, G., Pacifico, S., Andreola, F., Lancellotti, I., & Barbieri, L. (2022). A New System of Sustainable Silico-Aluminous and Silicate Materials for Cultivation Purpose within Sustainable Buildings: Chemical-Physical, Antibacterial and Cytotoxicity Properties. Applied Sciences, 12(1), 434. https://doi.org/10.3390/app12010434
